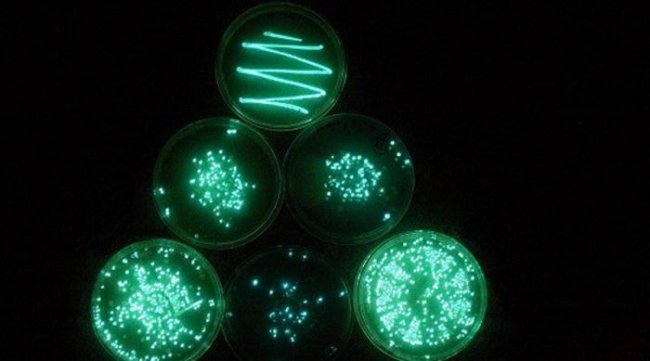

О Луне и Марсе мы знаем больше, чем о глубинах собственной планеты. В самом глубоком ее месте побывало всего три человека, и видели они на расстояние вытянутой руки. Множество явлений и находок из океана до сих пор непонятны ученым, и кто знает, сколько их еще еще ждет своего часа внизу, в черной бездне.
Содержание
- 1 Балтийская аномалия
- 2 Мегалодон из Марианской впадины
- 3 Гигантский кальмар
- 4 Голос Ктулху
- 5 Потерянные субмарины
- 6 Глубоководный фотосинтез
- 7 Гигантский змей
Балтийская аномалия
Некоторые считают Балтийскую аномалию инопланетным артефактом возраста Ледникового периода, другие полагают, что это противолодочное устройство нацистов. Удивительнее всего, что вся электроника перестает работать в радиусе 650 метров от предмета.
Мегалодон из Марианской впадины
Японские ученые исследовали морскую жизнь на дне глубоководного залива Суруга и в какой-то момент решили приманить сюда хищников. Чего они точно не ожидали, так это появления акулы, длина которой была не менее 30 метров. Сегодня считается, что это один из немногих доживших до наших дней мегалодонов.
Гигантский кальмар
Долгое время гигантские кальмары считались всего лишь выдумкой матросов. Однако, первый живой кальмар был снят на камеру в июле 2012 года: он достигал 13 метров в длину и весил около полутонны.
Голос Ктулху
В 1997 году гидрофоны Национального управления по проблемам океана и атмосферы (NOAA) уловили один из самых громких звуков из когда-либо записанных у южного побережья Южной Америки. Звук, названный Bloop, был зафиксирован двумя гидрофонами на расстоянии примерно 4800 км. друг от друга. Он напоминал звук морского животного, но громкость звука была настолько велика, что его не могло издать морское существо, известное науке. Для удобства ученые окрестили звук «Голосом Ктулху» — кто знает, может это и в самом деле пробудился страшный зверь из книг Лавкрафта.
Потерянные субмарины
В 1968 году четыре страны (Россия, США, Израиль и Франция) в одно и то же время потеряли свои субмарины. Поиски результатов не дали, хотя квадраты пребывания подводных лодок неоднократно проверялись.
Глубоководный фотосинтез
На дне океана не может быть солнечного света, но некоторые бактерии вблизи гидротермальных жерл используют тусклое красное свечение, чтобы фотосинтезировать и производить пищу для себя. Ученые все еще пытаются понять, как такое вообще возможно.
Гигантский змей
По мнению многих океанологов, молодой морской змей может достигать одиннадцати метров в длину. Еще сто лет назад встреча с такой тварью в открытом море стоила матросам седых волос, но сегодня ученые стоят чуть ближе к пониманию этого странного создания.